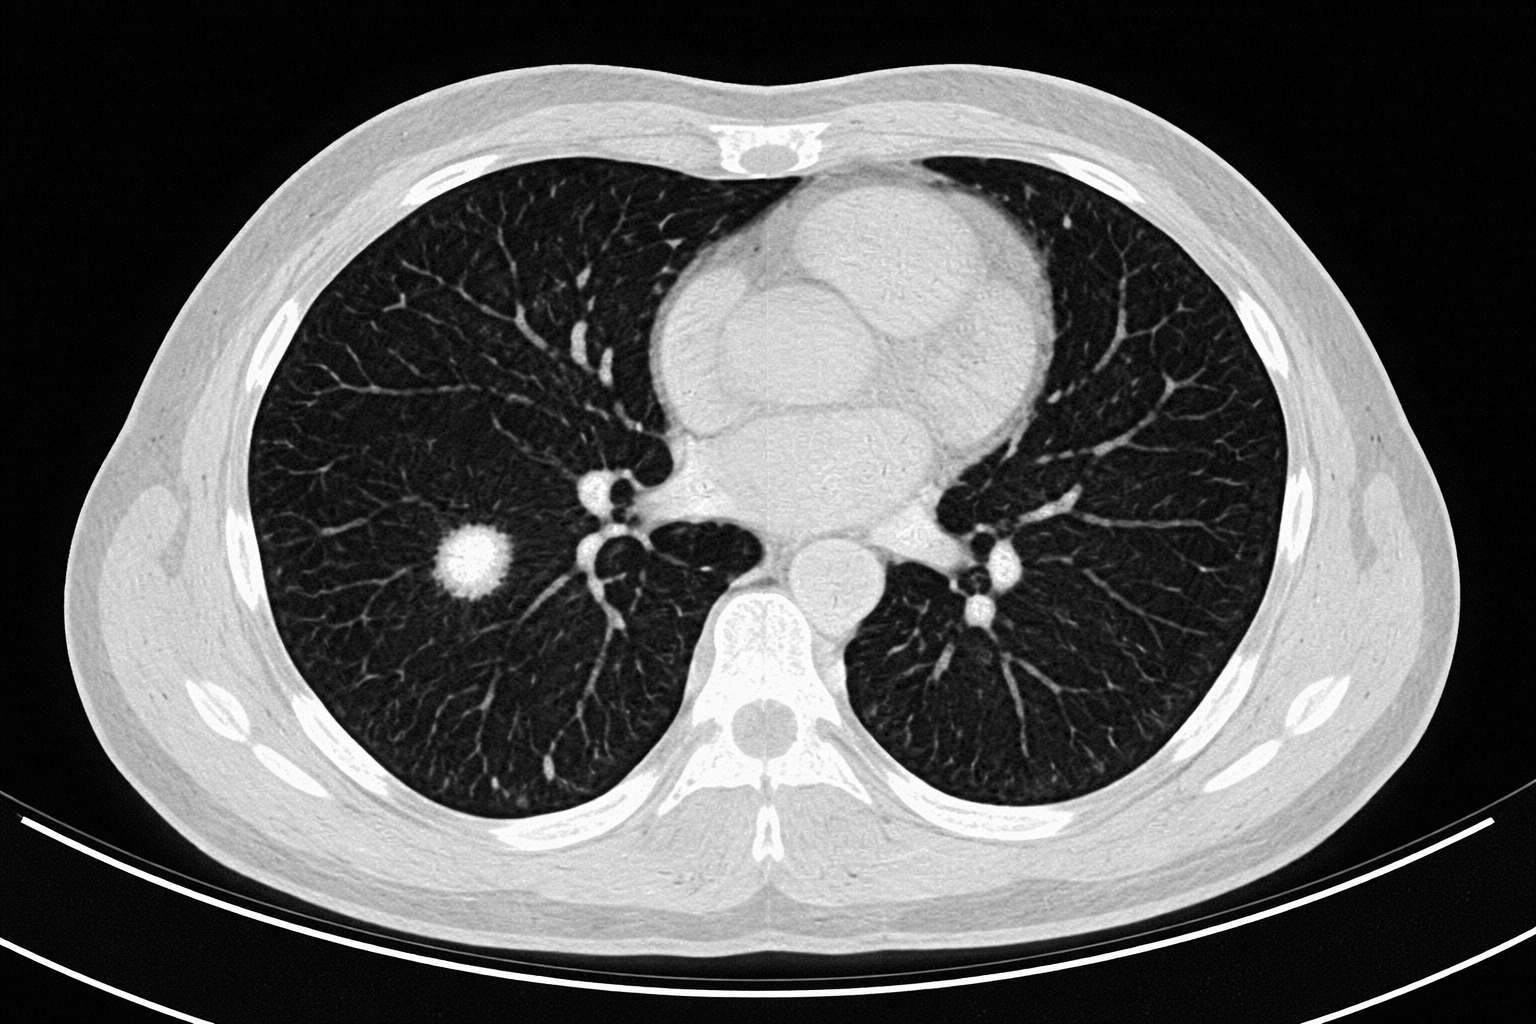
Incidental Pulmonary Nodules: Differentials and Diagnostic Imaging

The Diagnostic Imaging Blog
…to help you learn diagnostic imaging pearls for common primary care presentations.
✨ Join NP Reasoning for weekly diagnostic imaging insights to strengthen your practice ✨
Developmental Dysplasia of the Hip (DDH): Diagnostic Imaging with Ultrasound vs. X-Ray
Learn the pros and cons of physical exam maneuvers, high risk features, and diagnostic imaging pearls for suspected developmental dysplasia of the hip (DDH).
Read time: 4-5 minutes
Incidental Pulmonary Nodules: Differentials and Diagnostic Imaging
Incidental pulmonary nodules are common, and often anxiety-provoking. This post walks through a practical, evidence-based approach to risk stratification, imaging interpretation, and follow-up, tailored for primary care clinicians.
Read time: 7-8 minutes
Sacral Dimples and Diagnostic Imaging
Learn when, and when NOT to order ultrasound for sacral dimples.
Read time: 3-4 minutes
Diagnostic Imaging for a Breast Lump (and other breast concerns)
Approach to Breast Lump: Learn high-yield history, physical exam, and diagnostic imaging tips for this common primary care presentation.
Read time: 6-7 minutes
Superficial Thrombophlebitis: Diagnosis, Ultrasound Imaging, and Management in Primary Care
Learn how to diagnose and manage superficial thrombophlebitis, including ultrasound interpretation, DVT risk, and evidence-based treatment strategies.
Palpitations Workup: ECG, Holter Monitor, Echocardiogram, and Stress Tests Explained
A practical guide to evaluating palpitations in primary care, including ECG interpretation, Holter monitoring, echocardiography, and stress testing with clinical pearls and pitfalls.
Multiple Sclerosis Diagnosis: MRI Findings, Imaging Protocols, and Interpretation Pearls for Clinicians
A practical guide to diagnosing multiple sclerosis with a focus on MRI imaging, interpretation pearls, and clinical red flags. Learn how to recognize MS in primary care.
Abdominal Aortic Aneurysm (AAA) Screening: Guidelines, Risks, and Follow-Up
Learn who should be screened for abdominal aortic aneurysm (AAA), major risk factors, guideline differences, and how to monitor detected aneurysms.
Read time: 5-6 minutes
Hepatic Hemangiomas on Ultrasound: How Primary Care Providers Should Interpret This Incidental Liver Lesion
Learn how to manage the common incidental finding of hepatic hemangiomas - to follow up, or not to follow up?
Read time: 5-6 minutes
Incidentaloma: Gallbladder Polyps
Incidentaloma: Gallbladder Polyps
What is your differential for a gallbladder polyp?
What do we do with this common incidental finding?
Read time: 4-5 minutes.
Vertebral Compression Fractures in Osteoporosis: Diagnostic Imaging Tips
Learn the key clinical signs, risk factors, and imaging clues to catch hidden vertebral compression fractures early to guide osteoporosis care.
Read time: 5-6 minutes
Constipation in Kids: Should we X-ray?
Constipation in Kids: Should we x-ray?
What is your differential for constipation in kids?
Should we order x-ray routinely?
Let’s find out!
Read time: 5-7 minutes.
Ankle Injury: When to order Imaging
Ankle injury: When to Scan
What is your differential for an ankle injury?
When should we order imaging?
Let’s find out!
Read time: 5-10 minutes.
Diagnostic Imaging: A Primer for the Nurse Practitioner
Let’s dive into Diagnostic Imaging Essentials:
What is the difference between x-ray, ultrasounds, CT, and MR?
What are some common indications for these diagnostic imaging tests?
What test characteristics do I need to consider before ordering these tests?
How confident are you with ordering these tests?
We answer all these questions and more!
Read time: 5-7 minutes.
Thyroid Ultrasound
What is your differential for a neck mass/lump?
When should we order a thyroid ultrasound?
How do we interpret thyroid ultrasound findings, including incidental nodules?
We answer all these questions and more!
Read time: 5-10 minutes.
Acute Leg Swelling
Cracking the Case of Acute Leg Swelling: How to Use Wells Criteria, D-Dimer, and Ultrasound for a Quick, Accurate Diagnosis. It’s all about pre-test probability!
Read time: 5-10 minutes.
Should I Order Imaging for Low Back Pain?
Low back pain is one of the most common primary care presentations. How confident are you with your differential diagnosis, when to order diagnostic imaging, and how to interpret radiology reports?
Read time: 5-10 minutes.
Diagnostic Approach to Dysphagia
We review 3 key mechanisms of dysphagia, differential diagnoses, and diagnostic imaging considerations. We review red flags you do not want to miss!
Knee Pain in Adults: When to Order Diagnostic Imaging
Knee pain is a common primary care presentation, and we need to be familiar with differential diagnoses and indications for diagnostic imaging.
Read time: 5-10 minutes.
Diagnostic Approach to Shoulder Pain
We review common etiologies of traumatic and non-traumatic shoulder pain, and when to consider diagnostic imaging.
(Read time: 8-10 minutes)
Join the Masterclass
Join 1000s of Nurse Practitioners improving their clinical reasoning
Free Community
Explore NP Reasoning at no cost.
- Weekly newsletter: succinct clinical updates + diagnostic pearls
- Access to select diagnostic imaging and primary care update videos
Masterclass
Master diagnostic reasoning & stay ahead of the curve
- Comprehensive weekly newsletter with guideline updates, clinical cases, and diagnostic approaches
- Access to an on-demand video library on diagnostic imaging and primary care topics
- 25% off charting templates + course discounts